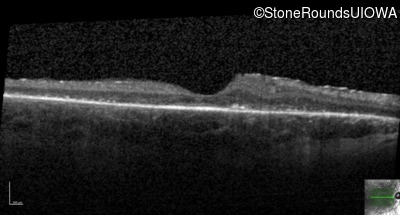
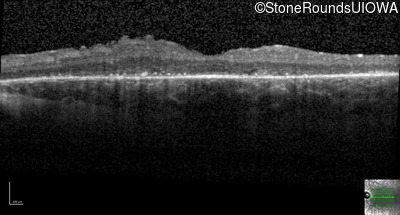
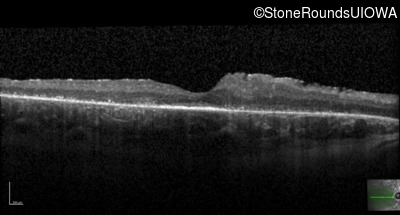
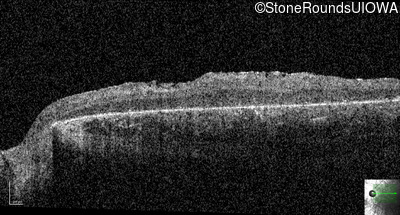
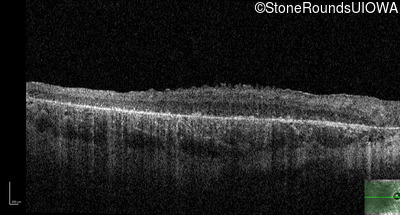
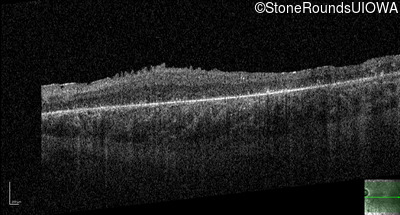

Case
SR114
Student Mode
Bardet Biedl Syndrome (IB2)
Male
Male
Hidden
SR114
Student Mode
Bardet Biedl Syndrome (IB2)
Male
Male
History
This 21 year old man first had difficulty seeing the blackboard in the 5th grade. Two years later he began having difficulty seeing in dim light. In high school he was approximately 50 pounds overweight, but was able to lose that weight with a strict diet.
| Age at visit: 21 years |
| Age at visit: 23 years |
| Age at visit: 27 years |
Diagnosis & molecular findings
| Disease | Gene | Allele 1 variant(s) | Allele 2 variant(s) | Inheritance mode |
|---|---|---|---|---|
| Bardet Biedl Syndrome | BBS1 | Met390Arg ATG>AGG | Arg277Lys AG(G)>AA(G) | AR |
Disease:
Gene:
Allele 1:
Met390Arg ATG>AGG
Allele 2:
Arg277Lys AG(G)>AA(G)
Inheritance:
AR